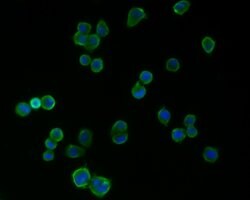
Invitrogen PSD-95 Monoclonal Antibody (B5-E6) 100 &mu;L; Unconjugated:Antibodies,

missing translation for 'onlineSavingsMsg'
Learn More
Learn More
Invitrogen™ PSD-95 Monoclonal Antibody (B5-E6)


Mouse Monoclonal Antibody
Brand: Invitrogen™ MA544605
This item is not returnable.
View return policy
Description
PSD-95 Monoclonal Antibody for Western Blot, ICC/IF, IHC (P), Flow
Post Synaptic Density 95 kDa (PSD-95), also known as synapse associated protein 90 kDa (SAP90), is one of a family of membrane-associated proteins found in the postsynaptic density in forebrain neurons and certain presynaptic structures in the cerebellum. Like other members of the family, PSD-95 has three 90 amino acid repeats called PDZ domains followed by an SH3 domain and a yeast guanylate kinase homology (GuK) domain. PSD-95 is believed to participate in the clustering of certain proteins, including NMDA receptors, Shaker-type potassium channels at the synaptic membrane in central nervous system (CNS) neurons. There are two principal modes of interaction between PSD-95 and other proteins. NMDA receptors and shaker-type potassium channels both share C-terminal sequence homology consisting of a threonine/serine-X-valine-COOH (T/SXV) motif. Other neuronal proteins that share this motif (beta 1 adrenergic receptor, some serotonin receptors, some sodium channel subunits, and additional potassium channel subunits), and some of these proteins may interact with PSD-95 by binding to its PDZ domains. Neuronal nitric oxide synthase (nNOS), which lacks the T/SXV motif but which has its own PDZ domain, has been shown to associate with PSD-95 in vitro through a pseudo-homotypic PDZ-PDZ interaction.
Specifications
| PSD-95 | |
| Monoclonal | |
| 2 mg/mL | |
| PBS with 0.2% BSA, 40% glycerol and 0.05% sodium azide; pH 7.4 | |
| P31016, P78352, Q62108 | |
| DLG4 | |
| Synthetic peptide within N-terminal human PSD95. | |
| 100 μL | |
| Primary | |
| Human, Mouse, Rat | |
| Antibody | |
| IgG2b |
| Flow Cytometry, Immunohistochemistry (Paraffin), Western Blot, Immunocytochemistry | |
| B5-E6 | |
| Unconjugated | |
| DLG4 | |
| discs large homolog 4; discs large MAGUK scaffold protein 4; discs, large homolog 4; discs, large homolog 4 (Drosophila); disks large homolog 4; Dlg4; Dlgh4; FLJ97752; FLJ98574; post synaptic density; postsynaptic density protein 95; post-synaptic density protein 95; PSD95; PSD-95; PSD-95 alpha 2b; PSD-95 beta; Sap90; SAP-90; SAP90A; Synapse-associated protein 90; synapse-associated protein SAP90; Tax interaction protein 15 | |
| Mouse | |
| Antigen affinity chromatography | |
| RUO | |
| 13385, 1742, 29495 | |
| Store at 4°C short term. For long term storage, store at -20°C, avoiding freeze/thaw cycles. | |
| Liquid |
Product Content Correction
Your input is important to us. Please complete this form to provide feedback related to the content on this product.
Product Title
Spot an opportunity for improvement?Share a Content Correction